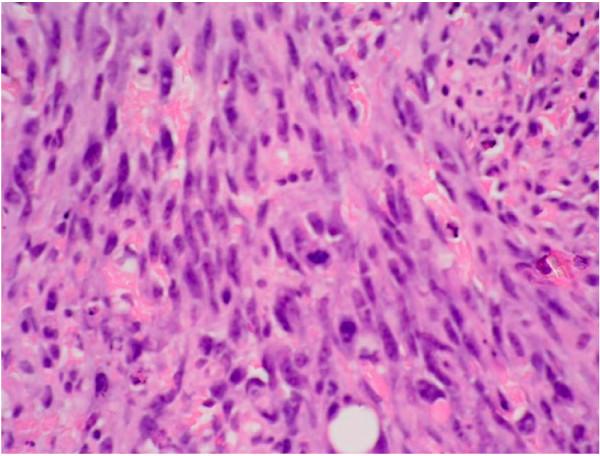

放射性诱导血管肉瘤是保乳手术后乳腺癌放疗的后遗症。
Radiation induced angiosarcoma a sequela of radiotherapy for breast cancer following conservative surgery.
作者信息
Tahir M, Hendry P, Baird L, Qureshi N A, Ritchie D, Whitford P
机构信息
Department of Surgery, Crosshouse Hospital, Kilmarnock, UK.
出版信息
Int Semin Surg Oncol. 2006 Sep 11;3:26. doi: 10.1186/1477-7800-3-26.
Radiation induced angiosarcomas (RIA) can affect breast cancer patients who had radiotherapy following conservative breast surgery. They are very rare tumors and often their diagnosis is delayed due to their benign appearance and difficulty in differentiation from radiation induced skin changes. Therefore it is very important that clinicians are aware of their existence. We report here a case of RIA followed by discussion and review of literature.
放射性诱导血管肉瘤(RIA)可发生于保乳手术后接受放疗的乳腺癌患者。它们是非常罕见的肿瘤,由于其外观良性且难以与放射性皮肤改变相鉴别,其诊断常常被延误。因此,临床医生了解它们的存在非常重要。我们在此报告一例放射性诱导血管肉瘤病例,并进行讨论及文献复习。